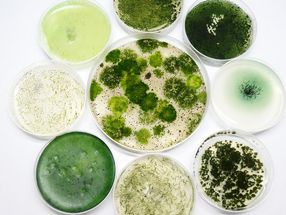

Genome sequencing - 146 News
Tip: You can further refine your news selection by departments, organizations, countries and industries.
Genome sequencing - 146 News
Tip: You can further refine your news selection by departments, organizations, countries and industries.
Advertisement
Genome sequencing - News by department
Genome sequencing - News by industry
Genome sequencing - News by country
Haven't found the right news yet?
The bionity.com news search
Start your targeted search now with a wide range of filter options. Our database includes an archive of 27,425 life science news from business and science, which you can search by topic and organization, filtered by time and geography.